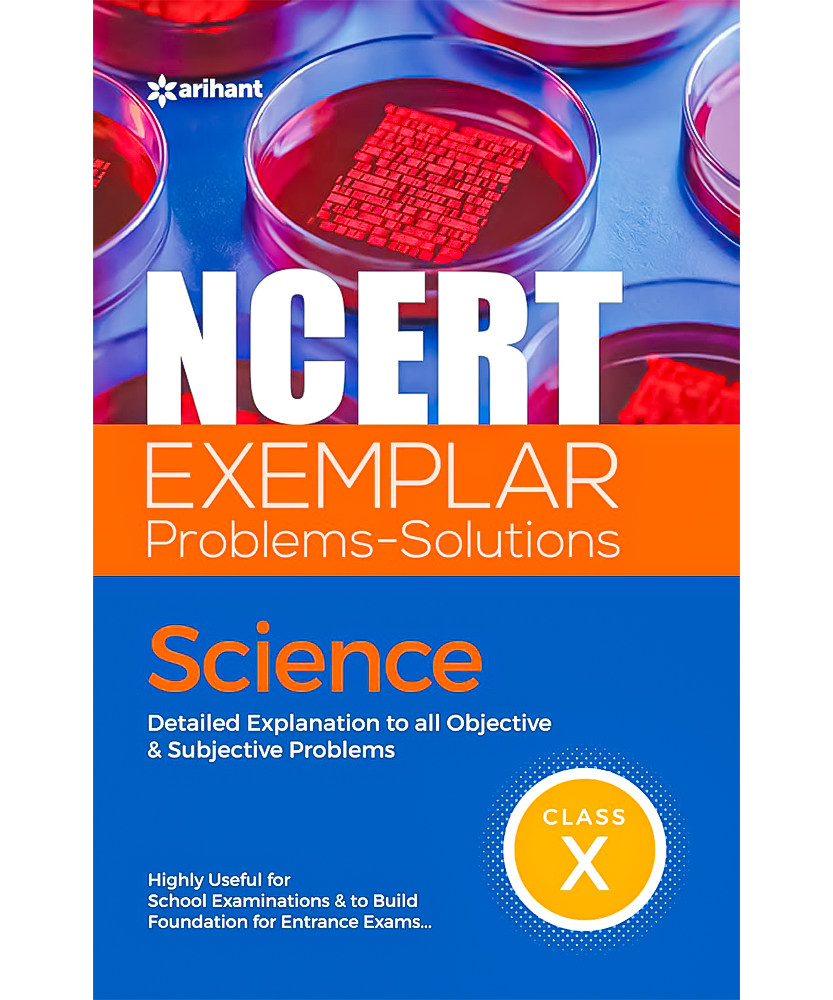
NCERT Exemplar Problems Solutions Science class 10th

1
/
of
1
arihant
NCERT Exemplar Problems Solutions Science class 10th
NCERT Exemplar Problems Solutions Science class 10th
Regular price
Rs. 140.00
Regular price
Rs. 190.00
Sale price
Rs. 140.00
Unit price
/
per
Shipping calculated at checkout.
Couldn't load pickup availability
Book Structure:
✍ Covers the entire Science Syllabus in 17 chapters
Book Key Features:
✍ Designed for class X students
✍ Explanatory & Accurate Solutions to all questions given in the NCERT Exemplar Science Book
✍Thinking Process tells how to solve a problem
✍ Notes are provided with special points
✍ Fully Support the practice of NCERT with the right approach
Why this Book?
✍ Latest edition serves as a comprehensive Exercise solution book
✍ Formulated to provide a large number of quality problems
✍ Highly useful for school exams and build the foundation for entrance exams
Share